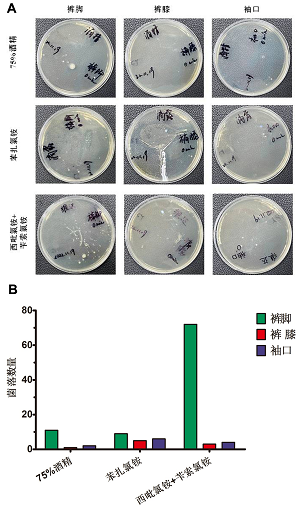
不同类型消毒湿巾对多种衣物材质消毒效果的研究与评价

梦游症在儿童中患病比例是10%左右。在现今快节奏的生活状态下梦游症频发更严重。梦游症患者梦游时有很多安全隐患,例如走出家门不仅对自身安全会造成危险,严重时也会影响他人危险。本课题研究制作一种基于IOT技术与图像识别技术的梦游者保护系统。让梦游症患者梦游时可以安全留在卧室,并提醒家人进行看护。根据此问题进行了线上调研,并根据调研结果设计制作了防护系统,其使用机器视觉识别卧室患者是否处于梦游状态,检测梦游后进行门窗的智能锁住,防止走出卧室发生危险。并通知家人进行前来看护。经测试,此系统各项功能正常运行,可以有效的保护梦游者。得到志愿者对此系统的评分正向反馈。此装置的出现可以让梦游症的严重?

篮球这项运动已经风靡了世界很多年,在如今不仅仅是学校,还有很多社区街道都会有属于自己的篮球场供人们活动。社区篮球场多为开放式的,避免不了出现球场乱入的情况。如小朋友宠物等跑入球场,造成意外受伤。本课题研究制作一种基于图像识别技术的球场乱入警示系统。让球员们能够在专注打球的时候知道突如其来的危险,保护运动者和误入者的安全。此装置运用图像识别技术,识别到球场内的人员或者物体。通过摄像头实时监测球场区域内的状态,只要球场内球员、篮球或其他物体的数量变多,则会触发警报。提醒打球人员出现乱入危险情况,需要注意安全。在球员们专注运动的前提下,保护他们的安全。这个方案能够应用在多个场景,不?

本项目旨在设计和制作一个用于单摆实验的装置,通过自动控制、数据采集和实时显示,提供了一个实践和学习的机会,加深对单摆实验的理解,并提高实验教学的效果和体验。该装置通过电磁铁的控制,实现了对摆动物的自动固定和释放,减少了人为操作的需求,提高了实验的准确性和稳定性。通过红外传感器进行摆动次数的计数和数据采集,通过0LED显示屏实时显示实验结果。通过实验验证,装置的测量准确性和一致性得到了验证,实验结果与标准值具有一致性。该装置具有可行性、科学性和实用性,能够满足单摆实验的控制和数据采集需求。在装置本身方面的创新点包括自动化控制、实时数据显示和重力加速度计算。在教学方向上的创新点包括实践与理论结合、数据采集与分析、自主学习与探究以及多媒体教学。装置的创新点使得该装置在教学中能够提供更多的实践和互动性,激发我们的学习兴趣和动力,提高学生对物理实验的理解和应用能力。综上所述,该装置在实验教学中具有重要的意义和应用价值

本研究旨在针对老年人中出现的认知障碍问题,设计并开发一款认知障碍挂坠装置,以解决阿尔茨海默症患者的认知障碍。目前大多数药物只能延缓治疗,缺乏有效的解决方案。本项目采用基于AI视觉摄像技术和语音合成技术的方法,通过APP进行数据储存,并利用ESP32掌控板处理数据,并通过语音合成模块进行输出。当AI视觉摄像头识别到人脸或对应场景时,掌控板会保存数据,并通过事先预存的人名或场景数据进行数据对比,然后语音合成模块将相应的名字和场景信息进行语音播报。通过控制变量进行测试,该认知障碍挂坠装置能够有效识别亲朋的人脸,并通过语音播报出他们的名字,帮助患者有效辨认具体是哪位亲朋。预计该装置将为老年人认知障碍的康复提供一?

本研究旨在设计一种可以合理规划宠物饮食的装置,以解决家庭中养多只猫时出现的抢食问题。当投喂猫粮时,尽管设置了两个放猫粮的盆子,但其中一只猫会除了吃自己面前的猫粮外,还会抢食另一只猫面前的猫粮。长期以往,抢食行为占上风的宠物更容易患上肥胖症,而经常被抢食的宠物可能会出现营养不良问题。本研究通过利用面部识别技术,设计了一种能够识别不同宠物的面部等身体特征,进而区分前来进食的宠物的装置。该装置能够自主控制各只宠物的饮食均衡和平等,从而解决了宠物之间的抢食问题。预计该装置将为家庭养多只猫的宠物主人提供一种便捷且有效的宠物饮食管理解决方案,降低肥胖和营养不良的风险,促进宠物的健康成长。

“起床困难症”多见于睡眠不足或者睡眠质量不高,这种情况多见于学生、成人,平时经常熬夜、学习或者上班导致睡眠严重不足,而对于此类问题常见于使用闹钟进行“强制起床”,又被称为“杀伤性叫醒”,且突然间的叫醒对人体的危害非常大,针对此问题,本项目设计并开发了一款基于骨传导技术的防“杀伤性叫醒”的安心睡眠枕。

节假日是出游高峰,在游乐园或者人流量较大的地方,除了正常的广播播报,听到最多的便是小朋友走丢后的寻人启事。孩子走丢后容易造成孩子身心受伤,然而在这种场合,监控往往会后置化,寻找效率非常低,无法进行精准实时监控。 随着游乐园面积增加以及人流量较大,光靠目前的摄像头无法实时追踪走失儿童的位置,也无法预判儿童的下一步的位置,因此我准备针对在游乐场儿童走失寻找时间过长的现状,设计了一款游乐场走失寻回系统。

玩具在儿童的成长过程中扮演着重要的角色,其带来的玩具安全问题也不容忽视,误食玩具就是其中的一项。本项目通过调研发现,0~6岁的婴幼儿误食玩具的潜在风险较大,设计一个防婴幼儿误食玩具提醒系统具有较大的实际价值和市场潜力。分析监护人防止婴幼儿误食玩具的场景,本项目首先确定了系统的核心功能:能够精准判断婴幼儿是否存在误食玩具的危险倾向;如有危险倾向,能够实时提醒监护人。

随着生活水平提高,上海居民非常关注饮水安全和健康,在饮用水用户问卷调查中,对饮用水的观感、口感高度关注。嗅味问题是饮用水感官评价的重要依据之一,主要由水中的藻类代谢物包括2-甲基异莰醇(2-MIB)和土臭素(GSM)引起。当前,我国常规处理工艺自来水厂(混凝→沉淀→过滤→消毒)对嗅味物质的去除效果约为10%~20%,因此,探索通过在常规工艺的基础上增加紫外高级氧化技术以实现嗅味物质有效控制。本课题探究如何有效解决水源水藻类暴发带来的嗅味物质增高问题,降低水源藻类爆发带来的水质安全风险,提供优质饮用水。

路面坑洞往往是由于重载货车对路面的磨损及雨水冲刷等造成路面损害,若不及时处理维护,坑洞将会持续扩大,对来往的行驶车辆造成影响甚至产生安全问题,因路面坑洞所造成的交通事故时常发生。为解决路面坑洞带来的损失,本文设计了一种基于卷积神经网络的路面坑洞识别系统。通过对YOLO目标检测模型的训练,有效实现了路面坑洞的检测。 本课题基于YOLO目标检测的路面坑洞检测系统能有效地解决路面坑洞所带来的行车安全问题,具有识别速度快、准确率高、智能化的优点。
自2019年以来,新型冠状病毒在全球范围内引起了广泛而严重的疫情。在疫情背景下,人们在外出回家之后通常需要先对衣物进行消毒晾晒,这已经逐渐形成了一种习惯。这种习惯是人类在面对不确定性风险时的一种正常反应,但由于目前缺乏比较权威的研究,针对不同的场景、不同的衣物材质,对比分析不同消毒方式的起效时间、消毒效果,造成人们在心理层面形成的压力以及经济层面的成本,比如不必要的消毒材料损耗。因此本课题的研究具有较强的社会意义与经济意义。基于以上想法,拟以最常见几种消毒湿巾为研究对象,通过收集多种衣物材质以及设定多个时间点,观察不同消毒方式处理之后在不同的静置时间情况下微生物的抑制情况(统计菌落数量),探究不同衣物

每年夏季,因野泳导致的溺亡悲剧频现,在野外水域,传统的措施,如警示牌、警示线,多在“防”字上下功夫,要实现“救”,需要耗费大量人力去及时发现。为破解“发现难、抢救不及时”这一难题,本项目设计开发了一个具备及时性、实时性、精准性和报警功能的防溺水监测系统。借助百度API接口,该系统利用基于卷积神经网络的人体姿态估计算法,通过对人体关键点的精准定位,加之具有较高精准性和鲁棒性的卷积神经网络姿态识别模型,将监测结果分为“正常”、“疑似”、“溺水”三类,并通过物联网将信息传输到管理端,语音播放结果,达到驱离、抢救的监测目的,结合APP的及时性,对管理员进行第一时间的提醒。

本项目针对图书馆检索不智能、找书不方便,甚至因图书错放导致根据检索结果找不到相应图书的痛点,提出了应用于图书馆场景下的书籍动态管理方案的算法设计。通过问卷调查发现,借阅图书作为图书馆的主要功能,在检索结果上不够智能、对图书定位不清晰、无法根据图书变动实时更新系统信息,读者查找图书要花费大量时间,因此,本项目希望借助计算机视觉技术中的Canny边缘检测,结合决策树算法,探究其在图书馆场景下的应用,预想在书架安装一个摄像头采集图像信息,利用边缘检测技术自动进行书架分层,再结合文字识别技术识别图书,对每一本图书进行精准定位;在检索方面,利用分类技术,返回与检索关键词相近的图书,提高返回结果的准确性。

生活中,食用隔夜菜是非常常见的,对67位对象进行调查发现,很多人对隔夜菜存在错误认知,轻视了放置时间过久的菜品潜在的巨大危害。之所以出现这样情况,很大程度上是因为大多数人认为只要菜品闻起来没有异味、吃起来正常就没问题,而事实上放置超过一定时间的食物就会产生各类致癌的物质,如亚硝酸盐,因此精准的判断菜品的新鲜度,给出是否可以食用的建议是非常重要的。本项目基于深度学习中的卷积神经网络,实现对菜品名称识别和菜品新鲜度的判断。首先,获取多张菜品图像,人工进行菜品名称和菜品新鲜度的标记,搭建YOLOv5网络模型进行训练,选取三成的图像作为验证集对模型进行调整优化,直至达到理想效果。

本研究旨在设计一个能够自动识别和判断小提琴演奏姿势的系统,以辅助演奏者在练习时保持正确的演奏姿势。通过分析当前相关产品的不足,我们发现现有产品要么只能进行音准训练,要么会对演奏体验产生不利影响。因此,本研究旨在设计一个具备精准性和实时性的人工智能“小老师”。我们深入研究了小提琴演奏姿势的基础规范,并结合基于OpenPose的人体姿态识别技术,设计了系统的功能。通过与专家进行调研,我们确定了小提琴标准演奏姿势的精确描述。我们使用Python语言开始了系统的开发。预计该系统能够有效帮助学习小提琴的人们在无指导教师的情况下保持正确的演奏姿势,提高学习效果,增强兴趣和信心。

外卖小哥的外卖配送过程中,由于配送时效性的问题,有时候会导致外卖丢失的状况发送,因此,本项目将语音识别与电磁锁结合起来,提出并实现了语音识别外卖箱,安全性高、成本适中、使用方便,其优势明显,创意突出。

由于太浦河沿岸集聚了织造、印染等企业含锑废水排放,造成太浦河本底锑浓度较高,上海金泽水库有突发锑污染的风险。金泽水库供水水厂均使用铝盐混凝剂,在突发锑污染的情况下,不能及时降低锑浓度,出厂水有超标的风险,饮水安全不能得到保障。本方案针对金泽水库水特定水质,以简化应急处理条件,不调来水pH为前提,进行不同铁盐混凝剂除锑工艺小试研究,得出适用于金泽水库水质特征的水厂应急除锑工艺参数,并进行应急方案可行性分析,为水厂去锑提供参考。

在滑雪单板的使用过程中,双腿被牢牢固定在单板上,严重限制了遭遇碰撞事故后,自我保护动作的施展。同时,固定住的双腿在翻滚时,会对膝盖造成不可避免的二次伤害。针对这个问题,本项目设计并开发了基于可控电磁铁的滑雪单板碰撞检测系统,拟解决滑雪单板遭遇碰撞后造成二次伤害的问题。基于可控电磁铁的滑雪单板碰撞检测装置能够有效解决单板安全问题和单板穿戴困难问题,具备穿戴方便、性能稳定、安全可靠的优点,在滑雪单板运动安全领域具有重要应用价值。

随着电子产品的愈加发达,学生休息时间几乎都在使用电子产品。全神贯注的学生无法发现自己处于斜眼状态,从而长期处在斜视状态。因此我准备针对青少年斜眼病高发的现状,设计一款放斜眼的动态监测系统。

打篮球的人有很多,并非每一个篮球场都有专业裁判做指挥,事实上,民间篮球运动90%都不标配裁判,或者裁判专业度不足,于是篮球场上经常会有因犯规分辨不清而产生的矛盾,严重时会发生打架等行为。本项目欲准备用基于AI识别技术代替篮球运动的裁判,节省了请专业裁判的金钱,也避免了因球员犯规或违例判断不一致产生的矛盾。该项目在当今讲求公平性和效率性的社会有重大意义,未来可以结合运动员大数据,生成每种运动特定的电子裁判系统,随着时间的推进,网球,足球,排球都逐步添加的电子裁判的系统,减少此类不公平的现象产生。
第 6 页,共 7 页 (共 136 个选题)